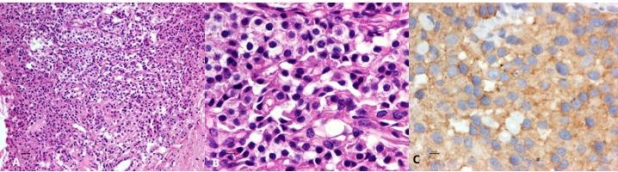
Figura 4

Caso clínico
Se presenta un caso de hemorragia digestiva alta por hipertensión portal segmentaria secundaria a compresión extrínseca por tumor neuroendocrino. Se trata de un hombre de 36 años que inicia 2 años previos con dolor abdominal en mesogastrio asociado a ictericia, coluria, cuadros de hematemesis, astenia, adinamia y pérdida de 6kg. Por endoscopía se documentó enfermedad varicosa hemorrágica esofágica que se trató con ligadura y beta bloqueadores. Posteriormente presentó cinco episodios de sangrado de tubo digestivo alto manejados con endoscopía y tratamiento médico, el último dos meses previo a su ingreso a este hospital, requiriendo transfusión sanguínea. Los exámenes de laboratorio a su ingreso: Hb 11,4gr/dL, Hematocrito 36,2%, Plaquetas 280.000/mm³. TP 11,50 seg, TTP 28,30 seg, INR 1,0. BT 0,47mg/dL, BD 0,06 mg/dL, BI 0,41mg/dL, ALT 33U/L, AST 41 U/L, FA 150 U/L, ALB 4, g/dL, Cr 0,95mg/dl. Ac Anti-LKM 2,3 U, Ac Anti-mitocondriales 5,2 U/mL, Ac anti-músculo liso negativos, Ac anti-nucleares moteado grueso 1:80; centriolar 1:80; citoplásmico 1:40. IgG 1734 mg/dL (subclase 4 171 mg/dL), IgA 358,20 mg/dL, IgM 85,80 mg/dL. Enzimas pancreáticas y Ca 19,9 (normales). Perfil de hepatitis crónica negativo. Cromogranina A sérica 18,5 nmol/l.

Por ultrasonido se demostró parénquima hepático normal y páncreas con aumento de volumen y ecogenicidad heterogénea. Por tomografía multifásica el páncreas mostró aumento de volumen en su totalidad, precontraste densidad heterogénea con zonas nodulares hiperdensas y calcificaciones, con atenuación promedio de 45UH, realce arterial con atenuación de 86UH, portal 112UH y disminución en fase venosa a 100UH. Además se observó colapso de la porción distal de la vena esplénica y circulación colateral en hilio esplénico, fondo gástrico y periesofágica (Fig. 1 y 2). La medición de gradientes hepáticos y angiografía de tronco celíaco con presión de vena suprahepática libre 12mmHg, presión enclavada 14mmHg, gradiente de 2mmHg, sin evidencia de shunts intrapancreáticos, hallazgos consistentes con hipertensión portal postsinusoidal (Fig. 2).

Se realiza gamagrafía con 99mTc-HYNIC-Octreotido y SPECT-CT de abdomen superior que mostró sobreexpresión de receptores de somatostatina en todo el parénquima pancreático, compatible con tumor neuroendócrino (Fig. 3). La endoscopía documentó várices fúndicas GOV 1 de Sarin y cambios por aplicación de cianocrilato y esclerosante en fondo y cuerpo gástrico. Por ultrasonido endoscópico se toman biopsias de cabeza, cuerpo y cola pancreática con diagnóstico de infiltración generalizada del páncreas por tumor neuroendócrino bien diferenciado, G1, Cromogranina (+), sinaptofisina (+) y Ki67<1%. Niveles de insulina, somatostatina y VIP negativos (Fig. 4).

Se propuso pancreatectomía total, que el paciente no aceptó por lo que está en manejo médico con Octreótido (Sandostatina Lar) 20mg IM y control para la hipertensión portal con Propanolol 80mg cada 12hrs, Cinitaprida 1mg cada 8hrs y Sucralfato 1gr cada 12hrs.

